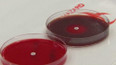
Konec účinku antibiotik? + rozhovor s J. Hrabákem

2. září 2019
Obsah dílu
Úspěch AfD v zemských volbách — Ničivá cesta hurikánu Dorian — Jednání o budoucnosti Afghánistánu — Konec účinku antibiotik? — Grónsko se proměňuje — Jeruzalém buduje nový hřbitov
Části dílu

Přehled dílů

2. ledna

22. prosince 2025
Ruský generál zemřel při výbuchu auta — Ukrajina útočí na ruský vojenský i ropný průmysl; Jednání o příměří + rozhovor s O. Soukupem — Ukrajinská Nová Pošta funguje už 24 let — Separatisté na jihu Jemenu na vzestupu — Vyšetřování masakru na pláži Bondi — Kritika za začerněné dokumenty o Epsteinovi — Izrael schválil dalších 19 osad + rozhovor s I. Kalhousovou — Irák sužuje extrémní vlna sucha

19. prosince 2025
Summit v Bruselu: Ukrajina zmrazená ruská aktiva nedostane; Nová pozice ČR — Putin sliboval klid zbraní na ukrajinské volby; Putin se setkal s novináři — Prezident Zelenskyj navštívil Polsko; Ukrajinské volby — Zákaz Robloxu v Rusku — Kennedy už není sám, doplnil ho Trump — Materiál na curlingové kameny je z ostrůvku

18. prosince 2025
EU rozhoduje o zmrazených ruských aktivech — Tchaj-wan: rekordní nákupy amerických zbraní — Příběhy obětí teroristických útoků v Austrálii — Zásah proti podezřelým z přípravy útoku v Austrálii — Zemřel válečný reportér Peter Arnett — Budoucnost Gazy stále provází nejistota — Chovy skotu ve Francii ohrožuje nová epidemie — Neposlušné mikrofony na summitu EU

17. prosince 2025
Sílící americký tlak na Venezuelu — Fentanyl jako zbraň hromadného ničení — Polsko posiluje bezpečnost — Výskyt lepry v EU + rozhovor s O. Černým — Krize bydlení v Austrálii dopadla i na studenty — Nové stanice metra v Římě

16. prosince 2025
Jednání o příměří na Ukrajině na mrtvém bodě + rozhovor s F. Mičánkem — Donald Trump žaluje BBC — Protivládní protesty na Slovensku — Polsko staví nejmodernější letiště v Evropě — Vyšetřování masakru na Bondi Beach + rozhovor s M. Marešem

12. prosince 2025
Muž, který symbolizuje deportace, je na svobodě + rozhovor s K. Březinovou — Ve východním Kongu opět vzplály boje — Ruská aktiva zůstanou zmrazená na neurčito — Potyčky a nadávky ve slovenském parlamentu — Videohra z Francie získala prestižní cenu — Pád bulharské vlády těsně před zavedením eura + rozhovor s P. Havlíčkem — Kosatky a delfíni spolupracují při lovu

11. prosince 2025
Ruská agrese na Ukrajině + rozhovor s M. Fornůskem — Násilí v ústavu pro mladé v Maďarsku — Ministerstvo zahraničí USA mění typ písma — Zkrachovalý rakouský magnát byl opět odsouzen — Americký vojenský tlak na Venezuelu — K bojkotu Izraele se připojil také Island

10. prosince 2025
EU hodlá snížit emise o devadesát procent + rozhovor s T. Halenkou — Letošní rok opět poznamenaly vysoké teploty — Washington chce podrobit turisty hlubší kontrole — Austrálie zakázala dětem používat sociální sítě — Soud nařídil zveřejnění Epsteinových spisů — Ukrajinský prezident připustil uspořádání voleb — Ukrajinci děkují za pomoc z EU: rozhovor se S. Prytulou — Italská kuchyně je světovým kulturním dědictvím — Betlém je po dvou letech plný světel

8. prosince 2025
Evropské země se ohrazují proti Washingtonu; Reparační půjčka pro Ukrajinu + rozhovor s M. Vokálkem — Nasazení žen v ukrajinské armádě — Boje na hranici mezi Thajskem a Kambodžou — Rok od pádu Asadova režimu v Sýrii — Seveřané čelí zimním depresím



